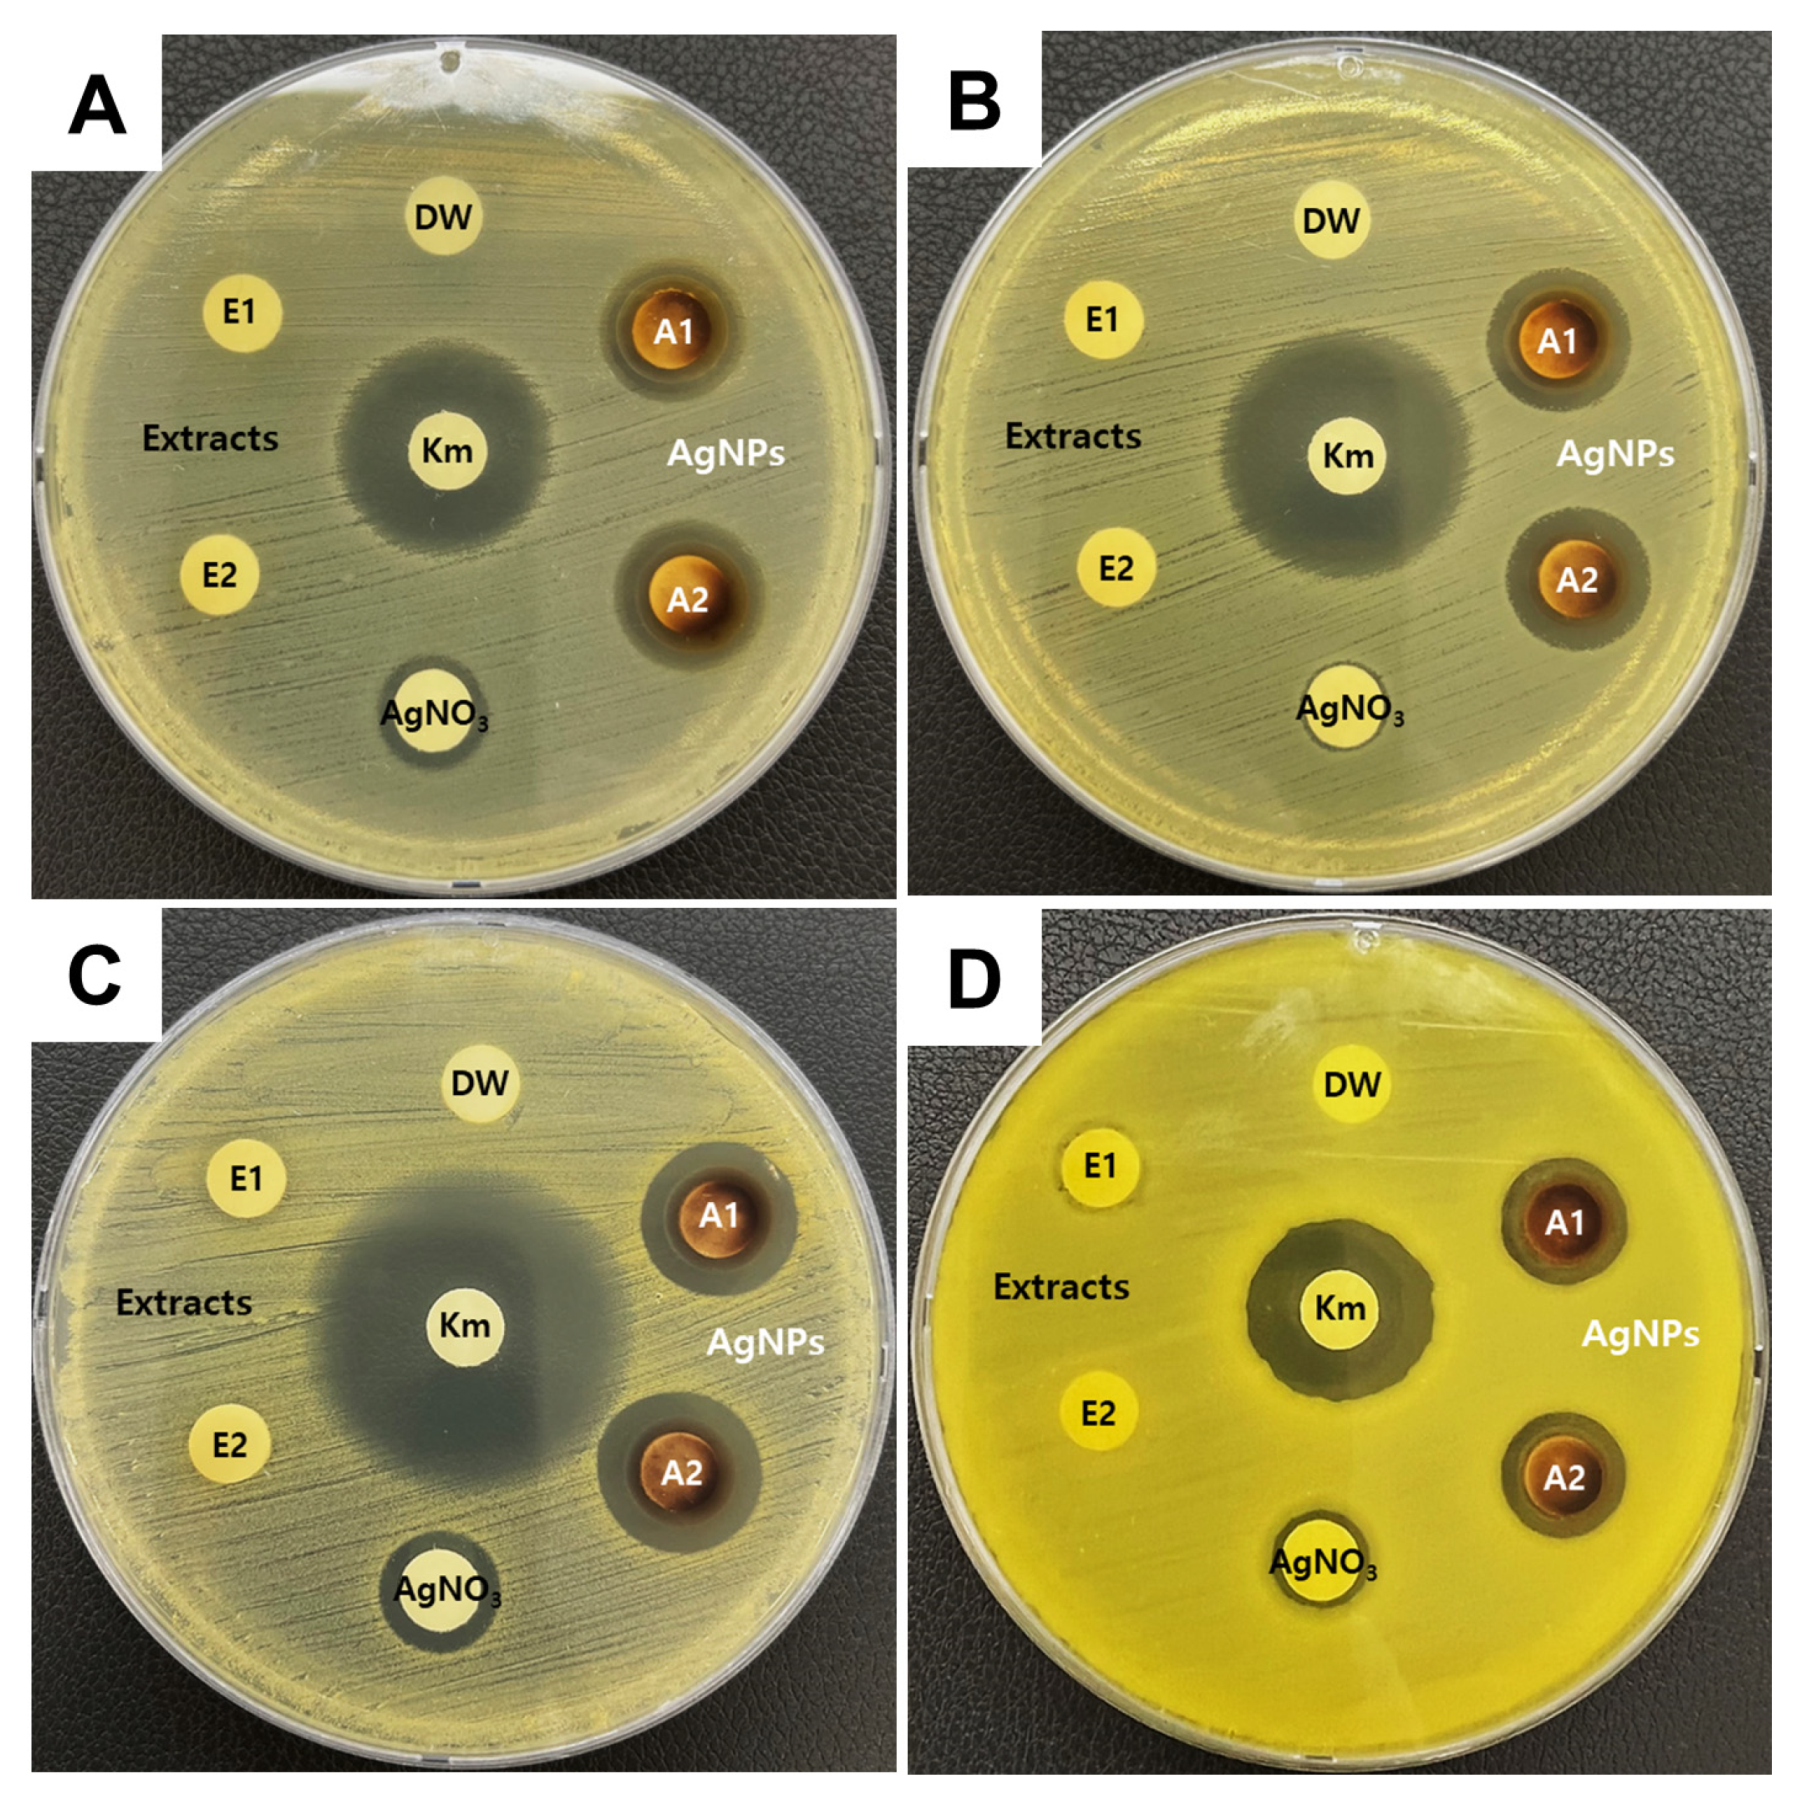
Microorganisms 12 02089 g004

Characterization and Antibacterial Activity of Silver Nanoparticles Synthesized from Oxya chinensis sinuosa (Grasshopper) Extract
Abstract
1. Introduction
2. Materials and Methods
2.1. Materials
2.2. O_extract Production and AgNP Synthesis
2.3. UV–Vis Spectroscopy Analysis
2.4. Dispersion Stability Analysis
2.5. TEM Analysis
2.6. FE-SEM Analysis
2.7. Particle Size and Surface Charge Analysis
2.8. XPS Analysis
2.9. HR-XRD Analysis
2.10. FTIR Analysis
2.11. Antibacterial Activity
3. Results and Discussion
3.1. Confirmation of Synthesis of AgNPs
3.2. Size and Shape Analysis of Synthesized AgNPs
3.3. Characterization of the Synthesized AgNPs
3.3.1. XPS Analysis
3.3.2. HR-XRD Analysis
3.3.3. FTIR Analysis
3.4. Antibacterial Activity of Synthesized AgNPs
4. Conclusions
Supplementary Materials
Author Contributions
Funding
Data Availability Statement
Conflicts of Interest
References
- Al-Hindi, R.R.; Teklemariam, A.D.; Alharbi, M.G.; Alotibi, I.; Azhari, S.A.; Qadri, I.; Alamri, T.; Harakeh, S.; Applegate, B.M.; Bhunia, A.K. Bacteriophage-based biosensors: A platform for detection of foodborne bacterial pathogens from food and environment. Biosensors 2022, 12, 905. [Google Scholar] [CrossRef] [PubMed]
- Gao, R.; Liu, X.; Xiong, Z.; Wang, G.; Ai, L. Research progress on detection of foodborne pathogens: The more rapid and accurate answer to food safety. Food Res. Int. 2024, 193, 114767. [Google Scholar] [CrossRef] [PubMed]
- Kumar, D.; Singh, R.; Upadhyay, S.K.; Verma, K.K.; Tripathi, R.M.; Liu, H.; Dhankher, O.P.; Tripathi, R.D.; Sahi, S.V.; Seth, C.S. Review on interactions between nanomaterials and phytohormones: Novel perspectives and opportunities for mitigating environmental challenges. Plant Sci. 2024, 340, 111964. [Google Scholar] [CrossRef]
- Zhao, Z.Y.; Li, P.J.; Xie, R.S.; Cao, X.Y.; Su, D.L.; Shan, Y. Biosynthesis of silver nanoparticle composites based on hesperidin and pectin and their synergistic antibacterial mechanism. Int. J. Biol. Macromol. 2022, 214, 220–229. [Google Scholar] [CrossRef]
- Majumder, S.; Huang, S.; Zhou, J.; Wang, Y.; George, S. Tannic acid-loaded halloysite clay grafted with silver nanoparticles enhanced the mechanical and antimicrobial properties of soy protein isolate films for food-packaging applications. Food Packag. Shelf Life 2023, 39, 101142. [Google Scholar] [CrossRef]
- Raza, M.A.; Ahmad, A.; Saeed, F.; Hussain, M.; Afzaal, M.; Rasheed, A. Maize bran arabinoxylans mediated green synthesis of silver nanoparticles and their incorporation in gelatin-based packaging film. Food Packag. Shelf Life 2024, 43, 101301. [Google Scholar] [CrossRef]
- Loo, Y.Y.; Rukayadi, Y.; Nor-Khaizura, M.A.R.; Kuan, C.H.; Chieng, B.W.; Nishibuchi, M.; Radu, S. In vitro antimicrobial activity of green synthesized silver nanoparticles against selected gram-negative foodborne pathogens. Front. Microbiol. 2018, 9, 1555. [Google Scholar] [CrossRef]
- Yan, X.; He, B.; Liu, L.; Qu, G.; Shi, J.; Hu, L.; Jiang, G. Antibacterial mechanism of silver nanoparticles in Pseudomonas aeruginosa: Proteomics approach. Metallomics 2018, 10, 557–564. [Google Scholar] [CrossRef]
- Li, W.R.; Xie, X.B.; Shi, Q.S.; Zeng, H.Y.; Ou-Yang, Y.S.; Chen, Y.B. Antibacterial activity and mechanism of silver nanoparticles on Escherichia coli. Appl. Microbiol. Biotechnol. 2010, 85, 1115–1122. [Google Scholar] [CrossRef]
- Lok, C.-N.; Ho, C.-M.; Chen, R.; He, Q.-Y.; Yu, W.-Y.; Sun, H.; Tam, P.K.-H.; Chiu, J.-F.; Che, C.-M. Silver nanoparticles: Partial oxidation and antibacterial activities. J. Biol. Inorg. Chem. 2007, 12, 527–534. [Google Scholar] [CrossRef]
- Xiu, Z.M.; Zhang, Q.B.; Puppala, H.L.; Colvin, V.L.; Alvarez, P.J.J. Negligible particle-specific antibacterial activity of silver nanoparticles. Nano Lett. 2012, 12, 4271–4275. [Google Scholar] [CrossRef] [PubMed]
- Keat, C.L.; Aziz, A.; Eid, A.M.; Elmarzugi, N.A. Biosynthesis of nanoparticles and silver nanoparticles. Bioresour. Bioprocess. 2015, 2, 47. [Google Scholar] [CrossRef]
- Ahmed, B.; Bilal Tahir, M.B.; Sagir, M.; Hassan, M. Bio-inspired sustainable synthesis of silver nanoparticles as next generation of nanoproduct in antimicrobial and catalytic applications. Mater. Sci. Eng. B 2024, 301, 117165. [Google Scholar] [CrossRef]
- Ahmadi, F.; Lackner, M. Green synthesis of silver nanoparticles from Cannabis sativa: Properties, synthesis, mechanistic aspects, and applications. ChemEngineering 2024, 8, 64. [Google Scholar] [CrossRef]
- Mahmoodi, N.M.; Karimi, B.; Mazarji, M.; Moghtaderi, H. Cadmium selenide quantum dot-zinc oxide composite: Synthesis, characterization, dye removal ability with UV irradiation, and antibacterial activity as a safe and high-performance photocatalyst. J. Photochem. Photobiol. B 2018, 188, 19–27. [Google Scholar] [CrossRef]
- Chakraborty, B.; Bhat, M.P.; Basavarajappa, D.S.; Rudrappa, M.; Nayaka, S.; Kumar, R.S.; Almansour, A.I.; Perumal, K. Biosynthesis and characterization of polysaccharide-capped silver nanoparticles from Acalypha indica L. and evaluation of their biological activities. Environ. Res. 2023, 225, 115614. [Google Scholar] [CrossRef]
- Zhang, X.-F.; Liu, Z.-G.; Shen, W.; Gurunathan, S. Silver nanoparticles: Synthesis, characterization, properties, applications, and therapeutic approaches. Int. J. Mol. Sci. 2016, 17, 1534. [Google Scholar] [CrossRef]
- He, J.; Feizipour, S.; Veisi, H.; Amraii, S.A.; Zangeneh, M.M.; Hemmati, S. Panax ginseng root aqueous extract mediated biosynthesis of silver nanoparticles under ultrasound condition and investigation of the treatment of human lung adenocarcinoma with following the PI3K/AKT/mTOR signaling pathway. Inorg. Chem. Commun. 2024, 160, 112021. [Google Scholar] [CrossRef]
- Ahmed, S.; Ahmad, M.; Swami, B.L.; Ikram, S. A review on plants extract mediated synthesis of silver nanoparticles for antimicrobial applications: A green expertise. J. Adv. Res. 2016, 7, 17–28. [Google Scholar] [CrossRef]
- Mondal, A.; Maity, S.; Mondal, A.; Mondal, N.K. Antibacterial, antibiofilm and larvicidal activity of silver nanoparticles synthesized from spider silk protein. Int. J. Biol. Macromol. 2024, 258, 128775. [Google Scholar] [CrossRef]
- Rumpold, B.A.; Schlüter, O.K. Nutritional composition and safety aspects of edible insects. Mol. Nutr. Food Res. 2013, 57, 802–823. [Google Scholar] [CrossRef]
- Kim, W.S.; Han, J.M.; Song, H.-Y.; Byun, E.-H.; Seo, H.S.; Byun, E.-B. Edible Oxya chinensis sinuosa—Derived protein as a potential nutraceutical for anticancer immunity improvement. Nutrients 2020, 12, 3236. [Google Scholar] [CrossRef]
- Kim, S.K.; Weaver, C.M.; Choi, M.K. Proximate composition and mineral content of five edible insects consumed in Korea. CyTA J. Food 2017, 15, 143–146. [Google Scholar] [CrossRef]
- Khamhaengpol, A.; Siri, S. Fluorescent light mediated a green synthesis of silver nanoparticles using the protein extract of weaver ant larvae. J. Photochem. Photobiol. B 2016, 163, 337–344. [Google Scholar] [CrossRef]
- Jakinala, P.; Lingampally, N.; Hameeda, B.; Sayyed, R.Z.; Khan M., Y.; Elsayed, E.A.; El Enshasy, H. Silver nanoparticles from insect wing extract: Biosynthesis and evaluation for antioxidant and antimicrobial potential. PLoS ONE 2021, 16, e0241729. [Google Scholar] [CrossRef]
- Kim, S.-M.; Choi, H.-J.; Lim, J.-A.; Woo, M.-A.; Chang, H.-J.; Lee, N.; Lim, M.-C. Biosynthesis of silver nanoparticles from Duchesnea indica extracts using different solvents and their antibacterial activity. Microorganisms 2023, 11, 1539. [Google Scholar] [CrossRef]
- Krishnaraj, C.; Jagan, E.G.; Rajasekar, S.; Selvakumar, P.; Kalaichelvan, P.T.; Mohan, N. Synthesis of silver nanoparticles using Acalypha indica leaf extracts and its antibacterial activity against water borne pathogens. Colloids Surf. B Biointerfaces 2010, 76, 50–56. [Google Scholar] [CrossRef]
- Zain, M.; Nayab, S.; Rashid, Z.; Aleem, A.; Raza, H.; Yousif, M.D. Biosynthesis and in vivo wound healing abilities of Dactyloctenium aegyptium-mediated silver nanoparticles used as hydrogel dressing. Process Biochem. 2024, 147, 31–38. [Google Scholar] [CrossRef]
- Shanmuganathan, R.; Brindhadevi, K.; Al-Ansari, M.M.; Al-Humaid, L.; Barathi, S.; Lee, J. In vitro investigation of silver nanoparticles synthesized using Gracilaria veruccosa—A seaweed against multidrug resistant Staphylococcus aureus. Environ. Res. 2023, 227, 115782. [Google Scholar] [CrossRef]
- He, M.; Han, Z.; Liang, Y.; Zhao, H.; Ji, X.; Ma, G.; Cui, Y.; Wang, L. Green synthesis of Ag nanoparticles using elm pod polysaccharide for catalysis and bacteriostasis. Int. J. Biol. Macromol. 2022, 213, 1078–1087. [Google Scholar] [CrossRef]
- Singh, R.; Singh, R.; Parihar, P.; Mani, J.V. Green synthesis of silver nanoparticles using Solanum sisymbriifolium leaf extract: Characterization and evaluation of antioxidant, antibacterial and photocatalytic degradation activities. Process Biochem. 2024, 143, 337–352. [Google Scholar] [CrossRef]
- Abdelghany, T.M.; Al-Rajhi, A.M.H.; Al Abboud, M.A.; Alawlaqi, M.M.; Ganash Magdah, A.; Helmy, E.A.M.; Mabrouk, A.S. Recent advances in green synthesis of silver nanoparticles and their applications: About future directions. A review. BioNanoScience 2018, 8, 5–16. [Google Scholar] [CrossRef]
- Kim, I.W.; Markkandan, K.; Lee, J.H.; Subramaniyam, S.; Yoo, S.; Park, J.; Hwang, J.S. Transcriptome profiling and in silico analysis of the antimicrobial peptides of the grasshopper Oxya chinensis sinuosa. J. Microbiol. Biotechnol. 2016, 26, 1863–1870. [Google Scholar] [CrossRef]
- Rafique, M.; Sadaf, I.; Rafique, M.S.; Tahir, M.B. A review on green synthesis of silver nanoparticles and their applications. Artif. Cells Nanomed. Biotechnol. 2017, 45, 1272–1291. [Google Scholar] [CrossRef]
- Biswas, K.; Ahamed, Z.; Dutta, T.; Mallick, B.; Khuda-Bukhsh, A.R.; Biswas, J.K.; Mandal, S.K. Green synthesis of silver nanoparticles from waste leaves of tea (Camellia sinensis) and their catalytic potential for degradation of azo dyes. J. Mol. Struct. 2024, 1318, 139448. [Google Scholar] [CrossRef]
- Li, H.F.; Pan, Z.C.; Chen, J.M.; Zeng, L.X.; Xie, H.J.; Liang, Z.Q.; Wang, Y.; Zeng, N.K. Green synthesis of silver nanoparticles using Phlebopus portentosus polysaccharide and their antioxidant, antidiabetic, anticancer, and antimicrobial activities. Int. J. Biol. Macromol. 2024, 254, 127579. [Google Scholar] [CrossRef]
- Yang, X.; Niu, Y.; Fan, Y.; Zheng, T.; Fan, J. Green synthesis of Poria cocos polysaccharides-silver nanoparticles and their applications in food packaging. Int. J. Biol. Macromol. 2024, 269, 131928. [Google Scholar] [CrossRef]
- Khorrami, S.; Zarrabi, A.; Khaleghi, M.; Danaei, M.; Mozafari, M.R. Selective cytotoxicity of green synthesized silver nanoparticles against the MCF-7 tumor cell line and their enhanced antioxidant and antimicrobial properties. Int. J. Nanomed. 2018, 13, 8013–8024. [Google Scholar] [CrossRef]
- Aziz, N.A.; Salleh, N.H.M.; Gopinath, S.C.B.; Kamaruddin, A.H.; Ridzuan, M.I.; Ahmad, N.A. Valorization of Momordica charantia seeds into phytogenically synthesized silver nanoparticles for the protection of oyster mushrooms against Trichoderma pleuroticola. J. Environ. Chem. Eng. 2023, 11, 111064. [Google Scholar] [CrossRef]
- Patel, M.; Kikani, T.; Saren, U.; Thakore, S. Bactericidal, anti-biofilm, anti-oxidant potency and catalytic property of silver nanoparticles embedded into functionalised chitosan gel. Int. J. Biol. Macromol. 2024, 262, 129968. [Google Scholar] [CrossRef]
- Teymourinia, H.; Sánchez, L.; Mollaie, F.; Ghalkhani, M.; Ramazani, A.; Hublikar, L.V.; Aminabhavi, T.M. Novel plasmonic Z-scheme-based photocatalysts and electrochemical aptasensor for the degradation and determination of epirubicin. Chem. Eng. J. 2024, 480, 148307. [Google Scholar] [CrossRef]
- Bao, Y.; Chen, K. AgCl/Ag/g-C3N4 hybrid composites: Preparation, visible light-driven photocatalytic activity and mechanism. Nanomicro Lett. 2016, 8, 182–192. [Google Scholar] [CrossRef]
- Sarkar, J.; Naskar, A.; Nath, A.; Gangopadhyay, B.; Tarafdar, E.; Das, D.; Chakraborty, S.; Chattopadhyay, D.; Acharya, K. Innovative utilization of harvested mushroom substrate for green synthesis of silver nanoparticles: A Multi–Response optimization approach. Environ. Res. 2024, 248, 118297. [Google Scholar] [CrossRef]
- Wasilewska, A.; Klekotka, U.; Zambrzycka, M.; Zambrowski, G.; Święcicka, I.; Kalska-Szostko, B. Physico-chemical properties and antimicrobial activity of silver nanoparticles fabricated by green synthesis. Food Chem. 2023, 400, 133960. [Google Scholar] [CrossRef]
- Ugwoke, E.; Aisida, S.O.; Mirbahar, A.A.; Arshad, M.; Ahmad, I.; Zhao, T.K.; Ezema, F.I. Concentration induced properties of silver nanoparticles and their antibacterial study. Surf. Interfaces 2020, 18, 100419. [Google Scholar] [CrossRef]
- Gheisari, F.; Reza Kasaee, S.; Mohamadian, P.; Chelliapan, S.; Gholizadeh, R.; Zareshahrabadi, Z.; Pooria Solhjoo, S.; Vafa, E.; Mosleh-Shirazi, S.; Mohammad Amani, A.; et al. Bromelain-loaded silver nanoparticles: Formulation, characterization and biological activity. Inorg. Chem. Commun. 2024, 161, 112006. [Google Scholar] [CrossRef]
- Li, Q.; Feng, T.; Li, H.; Wang, Z.; Wei, X.; Liu, J. Green synthesis of silver nanoparticles using endophytic bacterium Bacillus zanthoxyli GBE11 and their antimicrobial activity. Biomass Convers. Bioref. 2024, 14, 13173–13185. [Google Scholar] [CrossRef]
- Granum, P.E.; Lindbäck, T. Bacillus cereus. In Food Microbiology: Fundamentals and Frontiers; Wiley: Hoboken, NJ, USA, 2012; pp. 491–502. [Google Scholar] [CrossRef]
- Metryka, O.; Wasilkowski, D.; Dulski, M.; Adamczyk-Habrajska, M.; Augustyniak, M.; Mrozik, A. Metallic nanoparticle actions on the outer layer structure and properties of Bacillus cereus and Staphylococcus epidermidis. Chemosphere 2024, 354, 141691. [Google Scholar] [CrossRef]
- Fan, X.; Yahia, L.; Sacher, E. Antimicrobial Properties of the Ag, Cu Nanoparticle System. Biology 2021, 10, 137. [Google Scholar] [CrossRef]
- El-Sapagh, S.H.; El-Zawawy, N.A.; Elshobary, M.E.; Alquraishi, M.; Zabed, H.M.; Nouh, H.S. Harnessing the power of Neobacillus niacini AUMC-B524 for silver oxide nanoparticle synthesis: Optimization, characterization, and bioactivity exploration. Microb. Cell Fact. 2024, 23, 220. [Google Scholar] [CrossRef]
- Kanniah, P.; Chelliah, P.; Thangapandi, J.R.; Gnanadhas, G.; Mahendran, V.; Robert, M. Green synthesis of antibacterial and cytotoxic silver nanoparticles by Piper nigrum seed extract and development of antibacterial silver based chitosan nanocomposite. Int. J. Biol. Macromol. 2021, 189, 18–33. [Google Scholar] [CrossRef]
- Carbone, M.; Donia, D.T.; Sabbatella, G.; Antiochia, R. Silver nanoparticles in polymeric matrices for fresh food packaging. J. King Saud Univ. Sci. 2016, 28, 273–279. [Google Scholar] [CrossRef]
- Li, W.; Li, L.; Zhang, H.; Yuan, M.; Qin, Y. Evaluation of PLA nanocomposite films on physicochemical and microbiological properties of refrigerated cottage cheese. J. Food Process Preserv. 2018, 42, e13362. [Google Scholar] [CrossRef]
- Koshy, R.R.; Reghunadhan, A.; Mary, S.K.; Sadanandan, S.; Jose, S.; Thomas, S.; Pothen, L.A. AgNP anchored carbon dots and chitin nanowhisker embedded soy protein isolate films with freshness preservation for active packaging. Food Packag. Shelf Life 2022, 33, 100876. [Google Scholar] [CrossRef]
- Trotta, F.; Da Silva, S.; Massironi, A.; Mirpoor, S.F.; Lignou, S.; Ghawi, S.K.; Charalampopoulos, D. Silver Bionanocomposites as Active Food Packaging: Recent Advances & Future Trends Tackling the Food Waste Crisis. Polymers 2023, 15, 4243. [Google Scholar] [CrossRef]
- Nie, P.; Zhao, Y.; Xu, H. Synthesis, applications, toxicity and toxicity mechanisms of silver nanoparticles: A review. Ecotox. Environ. Safe 2023, 253, 114636. [Google Scholar] [CrossRef]
- Gallocchio, F.; Cibin, V.; Biancotto, G.; Roccato, A.; Muzzolon, O.; Carmen, L.; Simonne, B.; Manodori, L.; Fabrizi, A.; Patuzzi, I.; et al. Testing nano-silver food packaging to evaluate silver migration and food spoilage bacteria on chicken meat. Food Addit. Contam. Part A-Chem. 2016, 33, 1063–1071. [Google Scholar] [CrossRef]
- El Mahdy, M.M.; Eldin, T.A.S.; Aly, H.S.; Mohammed, F.F.; Shaalan, M.I. Evaluation of hepatotoxic and genotoxic potential of silver nanoparticles in albino rats. Exp. Toxicol. Pathol. 2015, 67, 21–29. [Google Scholar] [CrossRef]
- Chi, H.; Xue, J.; Zhang, C.; Chen, H.; Li, L.; Qin, Y. High Pressure Treatment for Improving Water Vapour Barrier Properties of Poly(lactic acid)/Ag Nanocomposite Films. Polymers 2018, 10, 1011. [Google Scholar] [CrossRef]
- Aouay, M.; Aguado, R.J.; Bayés, G.; Fiol, N.; Putaux, J.L.; Boufi, S.; Delgado-Aguilar, M. In-situ synthesis and binding of silver nanoparticles to dialdehyde and carboxylated cellulose nanofibrils, and active packaging therewith. Cellulose 2024, 31, 5687–5706. [Google Scholar] [CrossRef]

| Source of AgNP Synthesis | Mean Size (nm) | Zeta Potential (mV) | Polydispersity Index (PDI) |
|---|---|---|---|
| O_extract | 111.8 ± 1.5 | −24.1 ± 0.9 | 0.226 |
| Wavenumber (cm−1) | Assignment | |
|---|---|---|
| O_AgNPs | O_extract | |
| 3286 | 3284 | O–H stretching vibration |
| 2933 | 2929 | C–H stretching vibration |
| 1652 | 1648 | C=O stretching vibration |
| 1538 | 1552 | N–H bending (amide II band) |
| 1384 | 1392 | C–N stretching vibration |
| 1247 | 1234 | C–N stretching vibration (amide Ⅲ band) |
| 1081 | 1070 | C–O stretching vibrations |
| 832 | – | C–H stretching vibration |
| Sample | S. Typhimurium | E. coli | S. aureus | B. cereus |
|---|---|---|---|---|
| Zone of Inhibition (mm) | ||||
| O_extract | NA | NA | NA | NA |
| O_AgNPs | 15.08 ± 0.45 | 15.03 ± 0.15 | 15.24 ± 0.66 | 13.30 ± 0.16 |
| AgNO3 | 12.19 ± 0.6 | 9.78 ± 0.43 | 10.81 ± 1.26 | 9.83 ± 0.14 |
| Antibiotics | 22.91 ± 0.13 | 26.45 ± 0.49 | 30.93 ± 0.27 | 18.5 ± 0.71 |
Disclaimer/Publisher’s Note: The statements, opinions and data contained in all publications are solely those of the individual author(s) and contributor(s) and not of MDPI and/or the editor(s). MDPI and/or the editor(s) disclaim responsibility for any injury to people or property resulting from any ideas, methods, instructions or products referred to in the content. |
© 2024 by the authors. Licensee MDPI, Basel, Switzerland. This article is an open access article distributed under the terms and conditions of the Creative Commons Attribution (CC BY) license (https://creativecommons.org/licenses/by/4.0/).
Share and Cite
Kim, S.-M.; Kim, T.-Y.; Choi, Y.-S.; Ok, G.; Lim, M.-C. Characterization and Antibacterial Activity of Silver Nanoparticles Synthesized from Oxya chinensis sinuosa (Grasshopper) Extract. Microorganisms 2024, 12, 2089. https://doi.org/10.3390/microorganisms12102089
Kim S-M, Kim T-Y, Choi Y-S, Ok G, Lim M-C. Characterization and Antibacterial Activity of Silver Nanoparticles Synthesized from Oxya chinensis sinuosa (Grasshopper) Extract. Microorganisms. 2024; 12(10):2089. https://doi.org/10.3390/microorganisms12102089
Chicago/Turabian StyleKim, Se-Min, Tai-Yong Kim, Yun-Sang Choi, Gyeongsik Ok, and Min-Cheol Lim. 2024. "Characterization and Antibacterial Activity of Silver Nanoparticles Synthesized from Oxya chinensis sinuosa (Grasshopper) Extract" Microorganisms 12, no. 10: 2089. https://doi.org/10.3390/microorganisms12102089
APA StyleKim, S.-M., Kim, T.-Y., Choi, Y.-S., Ok, G., & Lim, M.-C. (2024). Characterization and Antibacterial Activity of Silver Nanoparticles Synthesized from Oxya chinensis sinuosa (Grasshopper) Extract. Microorganisms, 12(10), 2089. https://doi.org/10.3390/microorganisms12102089







